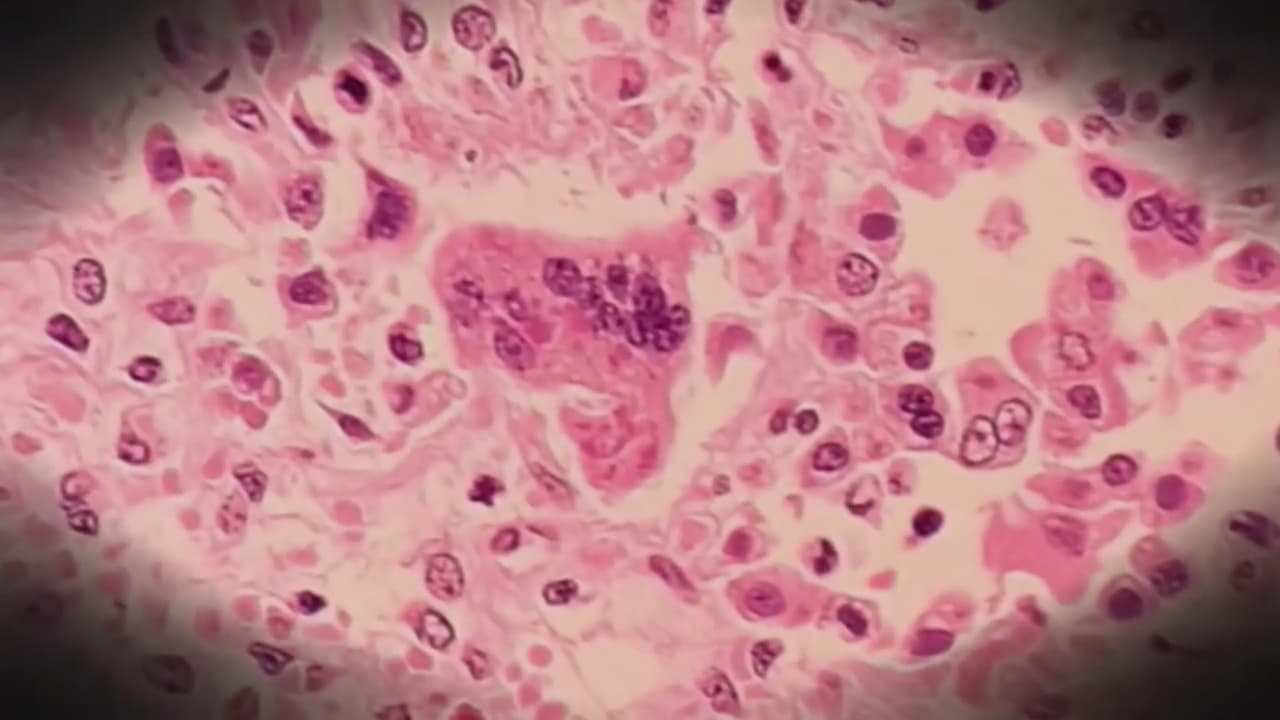

Cinco aeropuertos de EEUU están en alerta para evitar la propagación del sarampión
Al menos 30 estados del país han registrado brotes este 2019. Los Centros para el Control y Prevención de Enfermedades reportaron 1,276 casos, lo que ha convertido a este en el peor año sobre el contagio en más de dos décadas. La mejor manera de protegerse es vacunándose.
Por:Univision
Publicado el 24 dic 19 - 07:33 AM EST.